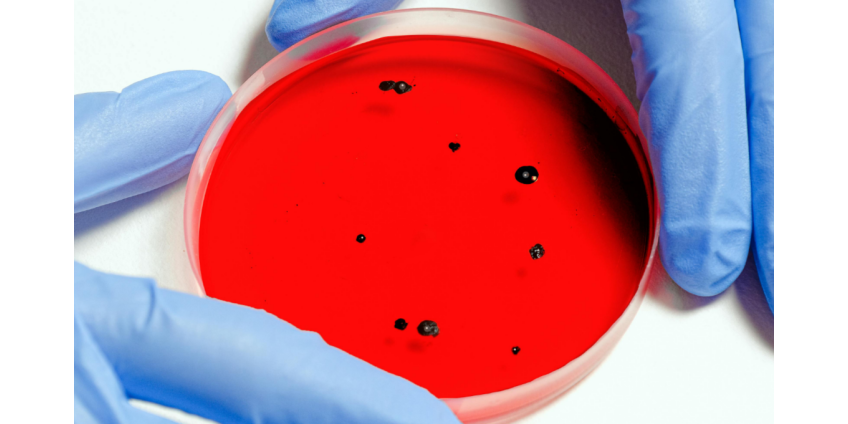

На западе Индии 15 человек умерли от внезапно вспыхнувшей неизвестной болезни. Об этом сообщает Hindustan Times.
«Число жертв загадочной лихорадки в городе Лакхпат в округе Кач штата Гуджарат возросло до 15 за последние восемь дней, но власти пока не смогли определить ее причину», — говорится в материале.
Неизвестная лихорадка унесла жизни десяти человек, включая детей, в период с 3 по 7 сентября. Затем было зафиксировано по меньшей мере еще пять летальных исходов, пишет издание.
Изначально загадочную болезнь считали пневмонией. Позже проведенные исследования исключили смерть из-за вируса гриппа H1N1, свиного гриппа, конго-крымской геморрагической лихорадки (ККГЛ), малярии и лихорадки денге. Анализы умерших направили в Национальный институт вирусологии в город Пуне.
«Результаты, как ожидается, поступят через день или два. Нам придется подождать результатов, чтобы выяснить, является ли это известным вирусом или чем-то новым», — заявил представитель местной администрации Амит Арора.
Ранее в Испании выявили десятки случаев заболевания новой загадочной болезнью. Пациенты страдали от вируса крысиного гепатита Е (Rocahepevirus ratti), который впервые был выявлен в Германии в 2010 году. Считалось, что человек не может им заразиться, но в 2018 году в Гонконге появился первый случай инфицирования человека.